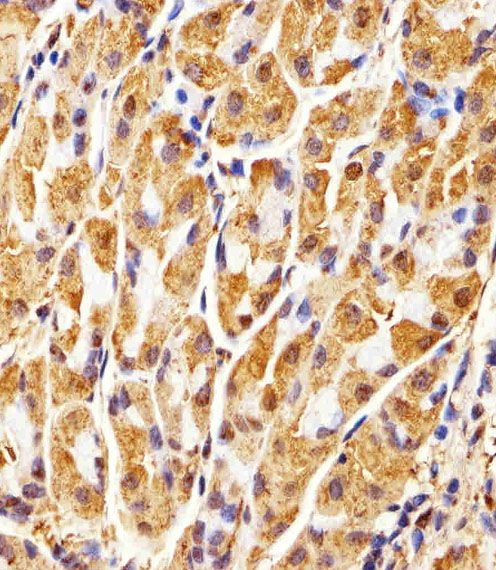

Mouse Monoclonal Antibody to GAPDH (Clone: 1A10A10)(Discontinued)
Figure 1: All lanes : Anti-GAPDH Antibody (10-6507) at 1:1000 dilution with Lane 1: A431 whole cell lysates, Lane 2: C6 whole cell lysates, Lane 3: Hela whole cell lysates, Lane 4: HUVEC whole cell lysates/proteins at 20 μg per lane. Secondary Goat Anti-mouse IgG, (H+L), Peroxidase conjugated at 1/10000 dilution. Predicted band size : 36 kDa.
Roll over image to zoom in
Shipping Info:
For estimated delivery dates, please contact us at [email protected]
| Format : | Purified |
| Amount : | 400 µl |
| Isotype : | Mouse IgG1 |
| Purification : | Protein G Chromatography |
| Content : | Purified monoclonal antibody supplied in PBS with 0.09% (W/V) sodium azide. |
| Storage condition : | Maintain refrigerated at 2-8°C for up to 2 weeks. For long term store at -20°C in small aliquots to prevent freeze-thaw cycles. |
IHC-P~1:25|| IF~1:25|| WB~ 1:2000~10000
For Research Use Only. Not for use in diagnostic/therapeutics procedures.
| Subcellular location: | Cytoplasm, Nucleus, Cytoplasm, Membrane, Cytoplasm |
| Post transnational modification: | Oxidative stress can promote the formation of high molecular weight disulfide-linked GAPDH aggregates, through a process called nucleocytoplasmic coagulation. Such aggregates can be observed in vivo in the affected tissues of patients with Alzheimer disease or alcoholic liver cirrhosis, or in cell cultures during necrosis. Oxidation at Met-46 may play a pivotal role in the formation of these insoluble structures. This modification has been detected in vitro following treatment with free radical donor (+/-)-(E)-4-ethyl-2-[(E)-hydroxyimino]-5-nitro-3-hexenamide. It has been proposed to destabilize nearby residues, increasing the likelihood of secondary oxidative damages, including oxidation of Tyr-45 and Met-105. This cascade of oxidations may augment GAPDH misfolding, leading to intermolecular disulfide cross-linking and aggregation. |
| BioGrid: | 108868. 233 interactions. |
|
There are currently no product reviews
|

.png)











